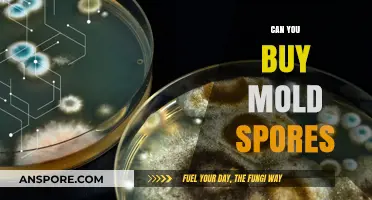
Where to Buy Mold Spores: A Comprehensive Guide for Researchers

In Los Angeles, the availability of mushroom spores for purchase is a topic of interest for both hobbyists and researchers, as it intersects with legal and scientific considerations. While mushroom spores themselves are not psychoactive and are generally legal to buy and possess in California, the laws surrounding their use and cultivation can be complex. Many vendors in Los Angeles and online offer spores for microscopy or educational purposes, but it’s crucial to understand that growing certain mushroom species, such as psilocybin-containing varieties, remains illegal under state and federal law. As a result, buyers must navigate these regulations carefully, ensuring their purchases comply with local statutes and are intended for lawful, non-cultivation purposes.
| Characteristics | Values |
|---|---|
| Legality of Purchasing Spores | Legal for microscopy and educational purposes; illegal for cultivation of psychoactive mushrooms (contains psilocybin) |
| Local Vendors in Los Angeles | Limited; some specialty stores or online retailers may ship to LA |
| Online Purchase Availability | Widely available from reputable vendors like SporeStore, Ralphsters Spores, and others |
| Shipping Restrictions | No specific restrictions to Los Angeles; standard shipping policies apply |
| Types of Spores Available | Psilocybe cubensis, Psilocybe azurescens, and other non-psychoactive species |
| Intended Use | Microscopy, research, education, and legal cultivation (non-psychoactive species) |
| Local Laws and Enforcement | California law prohibits cultivation of psychoactive mushrooms; spores themselves are not regulated |
| Community and Resources | Online forums, local mycology clubs, and educational workshops available in LA |
| Price Range | $10 to $50 per spore syringe or print, depending on species and vendor |
| Delivery Time | Typically 2-5 business days for online orders shipped to Los Angeles |
Explore related products
What You'll Learn

Legal status of mushroom spores in Los Angeles
In Los Angeles, the legal status of mushroom spores hinges on their intended use. California law, like federal law, distinguishes between spores themselves and the cultivation of psychoactive mushrooms. Spores are legal to buy, sell, and possess because they do not contain psilocybin, the controlled substance found in mature mushrooms. However, growing these spores into mushrooms that produce psilocybin is illegal under both state and federal law. This distinction creates a gray area where vendors can legally sell spores for "research or educational purposes," but buyers must navigate the legal risks of cultivation.
For those considering purchasing mushroom spores in Los Angeles, understanding the legal boundaries is crucial. Vendors often label spores as "not for human consumption" to comply with regulations. While possession of spores is not a criminal offense, cultivating them into psychoactive mushrooms can lead to serious legal consequences, including fines and potential imprisonment. Local law enforcement and prosecutors may prioritize cases involving large-scale cultivation or distribution, but even small-scale growers are not immune to legal scrutiny. Always verify the legitimacy of vendors and their compliance with state laws before making a purchase.
A comparative analysis of Los Angeles to other regions reveals a consistent pattern: spores are legal, but cultivation is not. This contrasts with jurisdictions like Oregon, where psilocybin has been decriminalized for therapeutic use under strict guidelines. In Los Angeles, the legal framework remains stricter, reflecting federal prohibitions. However, the growing interest in psychedelic research and advocacy may influence future policy changes. For now, residents must adhere to current laws while staying informed about potential legislative shifts.
Practical tips for buying mushroom spores in Los Angeles include researching reputable vendors who specialize in spore syringes or prints for microscopy and taxonomy studies. Avoid vendors making implicit claims about cultivation or consumption. Keep documentation of your purchase and intended use for research to demonstrate compliance if questioned. Additionally, consider joining local mycology clubs or forums to stay updated on legal developments and best practices. While the legal landscape is clear-cut, responsible engagement with this topic ensures both compliance and safety.
Can Spores Survive the Journey to Space? Exploring Microbial Resilience
You may want to see also

Local stores selling mushroom spores in LA
In Los Angeles, mushroom enthusiasts seeking spores for cultivation or study have several local options to explore. Stores like The Green Man Store in North Hollywood and The Mushroomery in Downtown LA specialize in mycology supplies, offering a variety of spore syringes and kits for legal, non-psilocybin mushroom species. These shops often cater to both beginners and experienced growers, providing educational resources alongside their products. For those interested in gourmet or medicinal mushrooms, such as lion’s mane or shiitake, these stores are invaluable resources.
For a more hands-on experience, LA Fungus in Silver Lake hosts workshops on mushroom cultivation, where attendees can purchase spores and learn techniques directly from experts. This approach is ideal for newcomers who want to avoid common pitfalls like contamination or improper substrate preparation. Workshops typically cover topics like sterilization, inoculation, and fruiting chamber setup, ensuring participants leave with the knowledge to succeed. Prices for spore syringes range from $20 to $50, depending on the species and quantity.
If you prefer a DIY approach, The Grow Store in Echo Park offers spore syringes and grow kits for species like oyster and reishi mushrooms. Their staff can guide you in selecting the right supplies, such as vermiculite, gypsum, and spawn bags, to create a successful home setup. For safety, always ensure your workspace is clean and sterile, as contamination can ruin a batch. Pro tip: maintain a humidity level of 85-95% during fruiting for optimal results.
Online directories like Mushroom Growers LA also list local vendors and farmers’ markets where spores and fresh mushrooms are sold. However, buying in person allows you to ask questions and inspect the quality of the product. Always verify the legality of the species you’re purchasing, as psilocybin spores are illegal in California for cultivation purposes. Stick to gourmet or medicinal varieties to stay compliant and focus on the practical benefits of growing your own mushrooms.
For those in the San Fernando Valley, Valley Mycology is a hidden gem offering rare spore strains and personalized advice. Their small, family-run operation prioritizes sustainability, using organic materials in their kits. They also sell pre-sterilized substrates, saving time for busy growers. Whether you’re aiming to reduce food waste by growing oyster mushrooms on coffee grounds or boosting your immune system with reishi, local stores in LA provide the tools and knowledge to turn your mycological dreams into reality.
Are Mushroom Spores Legal in Alabama? Understanding the Current Laws
You may want to see also

Online vendors shipping spores to Los Angeles
For those in Los Angeles seeking to cultivate mushrooms, online vendors offer a convenient solution by shipping spores directly to your doorstep. These vendors cater to both novice growers and experienced mycologists, providing a variety of spore syringes and kits for different mushroom species. Popular options include Psilocybe cubensis, Lion’s Mane, and Reishi, each with unique growing requirements and benefits. Most vendors ensure discreet packaging to maintain privacy, a critical feature for those in urban areas like Los Angeles.
When selecting an online vendor, consider their reputation and product quality. Look for reviews and testimonials to gauge reliability, as the legality of spore possession varies by region. In California, while cultivating psychoactive mushrooms is illegal, possessing spores for microscopy or non-cultivation purposes is generally permitted. Reputable vendors often include detailed instructions, ensuring even beginners can navigate the process. For instance, a typical spore syringe contains 10-20 ml of spore solution, sufficient for multiple slides or inoculations if used correctly.
Shipping times to Los Angeles are usually swift, with most vendors offering expedited options for an additional fee. Some vendors, like SporeStore and Ralphsters Spores, are known for their fast delivery and high-quality products. Always verify the vendor’s shipping policies, as delays can affect spore viability. Proper storage upon receipt is crucial—store spores in a cool, dark place, ideally between 4°C and 8°C, to preserve their longevity.
For those new to mycology, starting with a beginner-friendly species like Oyster mushrooms is advisable. These spores are hardy and grow quickly, providing a rewarding experience. Advanced growers might explore exotic varieties like Pink Buffalo or Penis Envy, which require more precise conditions but yield unique results. Regardless of experience level, always prioritize sterile techniques to avoid contamination, a common pitfall in mushroom cultivation.
In conclusion, online vendors make it feasible for Los Angeles residents to access mushroom spores legally and efficiently. By choosing a reputable vendor, understanding shipping logistics, and following best practices, growers can successfully cultivate mushrooms for study or consumption. Always stay informed about local laws and ethical considerations to ensure a responsible and rewarding experience.
Can Pseudomonas Form Spores? Unraveling the Bacterial Survival Mystery
You may want to see also
Explore related products
$16.98

Regulations for buying spores in California
In California, purchasing mushroom spores is legal, but the intent behind the purchase is what matters most. Spores themselves are not classified as controlled substances under state law because they do not contain psilocybin, the psychoactive compound found in grown mushrooms. However, cultivating these spores into mushrooms that produce psilocybin is illegal under both California and federal law. This distinction creates a regulatory gray area: while you can legally buy spores for research, microscopy, or educational purposes, using them to grow mushrooms for consumption is prohibited.
For those in Los Angeles, numerous online vendors and local shops offer mushroom spores, often marketed as "for microscopy use only." These vendors typically include disclaimers emphasizing that their products are not intended for cultivation. It’s crucial to read and adhere to these warnings, as law enforcement agencies in California actively monitor and prosecute illegal mushroom cultivation. Penalties for growing psilocybin-containing mushrooms can include fines, imprisonment, or both, depending on the scale of the operation.
One practical tip for buyers is to ensure the vendor explicitly states the spores are for microscopy or research purposes. Reputable sellers often include detailed instructions on proper handling and storage, reinforcing the legal use of their products. Additionally, keeping receipts and documentation of your purchase can serve as evidence of lawful intent if questioned by authorities. While the regulations may seem restrictive, they are designed to balance scientific and educational interests with public safety concerns.
Comparatively, California’s approach to spore regulation differs from states like Idaho and Georgia, where even possessing spores is illegal. This leniency reflects California’s progressive stance on drug policy, particularly with the decriminalization of psilocybin in certain cities. However, it’s essential to distinguish between decriminalization and legalization: while possessing small amounts of psilocybin mushrooms may not result in severe penalties in some areas, cultivating them remains a criminal offense statewide.
In conclusion, buying mushroom spores in Los Angeles is legal, but the purpose of the purchase is critical. By understanding and adhering to California’s regulations, individuals can explore the fascinating world of mycology without risking legal consequences. Always prioritize research and education over cultivation, and stay informed about evolving laws in this dynamic field.
Are Spore Syringes Legal in the UK? A Comprehensive Guide
You may want to see also

Best spore syringe brands available in LA
In Los Angeles, the availability of mushroom spores hinges on their intended use—microscopy and research, not cultivation. For enthusiasts seeking spore syringes, several reputable brands stand out, offering quality products that comply with legal guidelines. Here’s a focused guide to the best options available in LA.
Analytical Insight: Top Brands and Their Unique Selling Points
Among the leading brands, Gorilla Mushroom Spores distinguishes itself with a wide variety of strains, including popular options like Golden Teacher and B+ spores. Their syringes are lab-grade, ensuring purity and viability for microscopy work. Another standout is Ralphsters Spores, known for their meticulous packaging and detailed strain information, making them a favorite among researchers. For those prioritizing affordability without compromising quality, SporeStore offers competitively priced syringes with consistent reviews for reliability.
Instructive Guide: How to Choose the Right Brand
When selecting a spore syringe brand in LA, consider three key factors: strain diversity, customer reviews, and shipping discretion. Brands like Premium Spores excel in offering rare strains, ideal for advanced researchers. Always verify that the brand ships to California, as some companies have regional restrictions. Additionally, opt for brands that provide tracking and secure packaging to ensure your order arrives intact.
Comparative Analysis: Quality vs. Price
While Purple Mushroom Spores offers premium syringes with a higher price tag, their spores are renowned for longevity and clarity under microscopy. In contrast, TheCap provides budget-friendly options, though some users report variability in spore count. For most hobbyists, mid-range brands like Spores 101 strike a balance, offering decent quality at a reasonable price.
Practical Tips for LA Residents
To maximize your purchase, store syringes in a cool, dark place to preserve viability. Always sterilize your equipment before use to avoid contamination. For beginners, start with common strains like Golden Teacher or Penis Envy, as they are easier to study. Remember, purchasing spores in LA is legal only for educational purposes—cultivation remains prohibited under federal law.
Many LA residents turn to online retailers, as local shops rarely stock spore syringes. Websites like Gorilla Mushroom Spores and Ralphsters Spores offer seamless shipping to the city, often with expedited options. For those preferring in-person guidance, some specialty stores in neighborhoods like Silver Lake or Venice may provide recommendations, though direct purchases are typically online. Always ensure the brand’s compliance with California’s legal framework to avoid complications.
Are Mould Spores Dangerous? Understanding Health Risks and Prevention
You may want to see also
Frequently asked questions
Yes, it is legal to buy mushroom spores in Los Angeles for microscopy and research purposes, as they do not contain psilocybin, the controlled substance found in grown mushrooms.
You can purchase mushroom spores online from reputable vendors or at local specialty stores that cater to microscopy and mycology enthusiasts.
While buying spores is legal, cultivating psilocybin mushrooms from them is illegal in California. Spores are sold strictly for research and educational purposes.
A variety of mushroom spores are available, including Psilocybe cubensis, Psilocybe azurescens, and other species, primarily for microscopy and taxonomic study.
Purchasing spores for legal purposes (microscopy, research) is not illegal. However, using them to cultivate psychoactive mushrooms is against the law and can result in legal consequences.